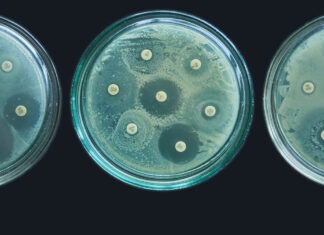

Sustainable pharmacy practice is the order of the day
A resounding theme at the FIP World Congress of Pharmacy and Pharmaceutical Sciences in Brisbane is the need for action on climate change.
From the President: Include pharmacists on the Medicare Benefits Schedule
A key tenet of PSA’s strategic intent is ensuring pharmacists are rewarded and recognised to reflect our high levels of training, our expertise and...
Navigating big career changes with PSA’s NSW Intern of the Year
Bridgette Mackley discusses something every pharmacist has experienced – the exciting, slightly terrifying transition from pharmacy student to intern and from intern to registered pharmacist.
Shameful: an under-served cohort
It is everyone’s responsibility to protect people with disability from medicine harm. We must all do more.
Disabilities, which can be impairments, activity limitations and...
Are pop-ups doing more harm than good?
Are decision-support tools the problem or the cure for patient safety? Australian Pharmacist investigates.
OECD sounds the alarm on antimicrobial resistance
A blistering session at the FIP Congress challenged policymakers and health professionals to slow the advance of antimicrobial resistance.





 Dr Phoebe Holdenson Kimura[/caption]
Dr Phoebe Holdenson Kimura[/caption]
 High-quality medicines reconciliation should ideally occur in the emergency department or soon after admission to the ward.
High-quality medicines reconciliation should ideally occur in the emergency department or soon after admission to the ward.
 AP
AP